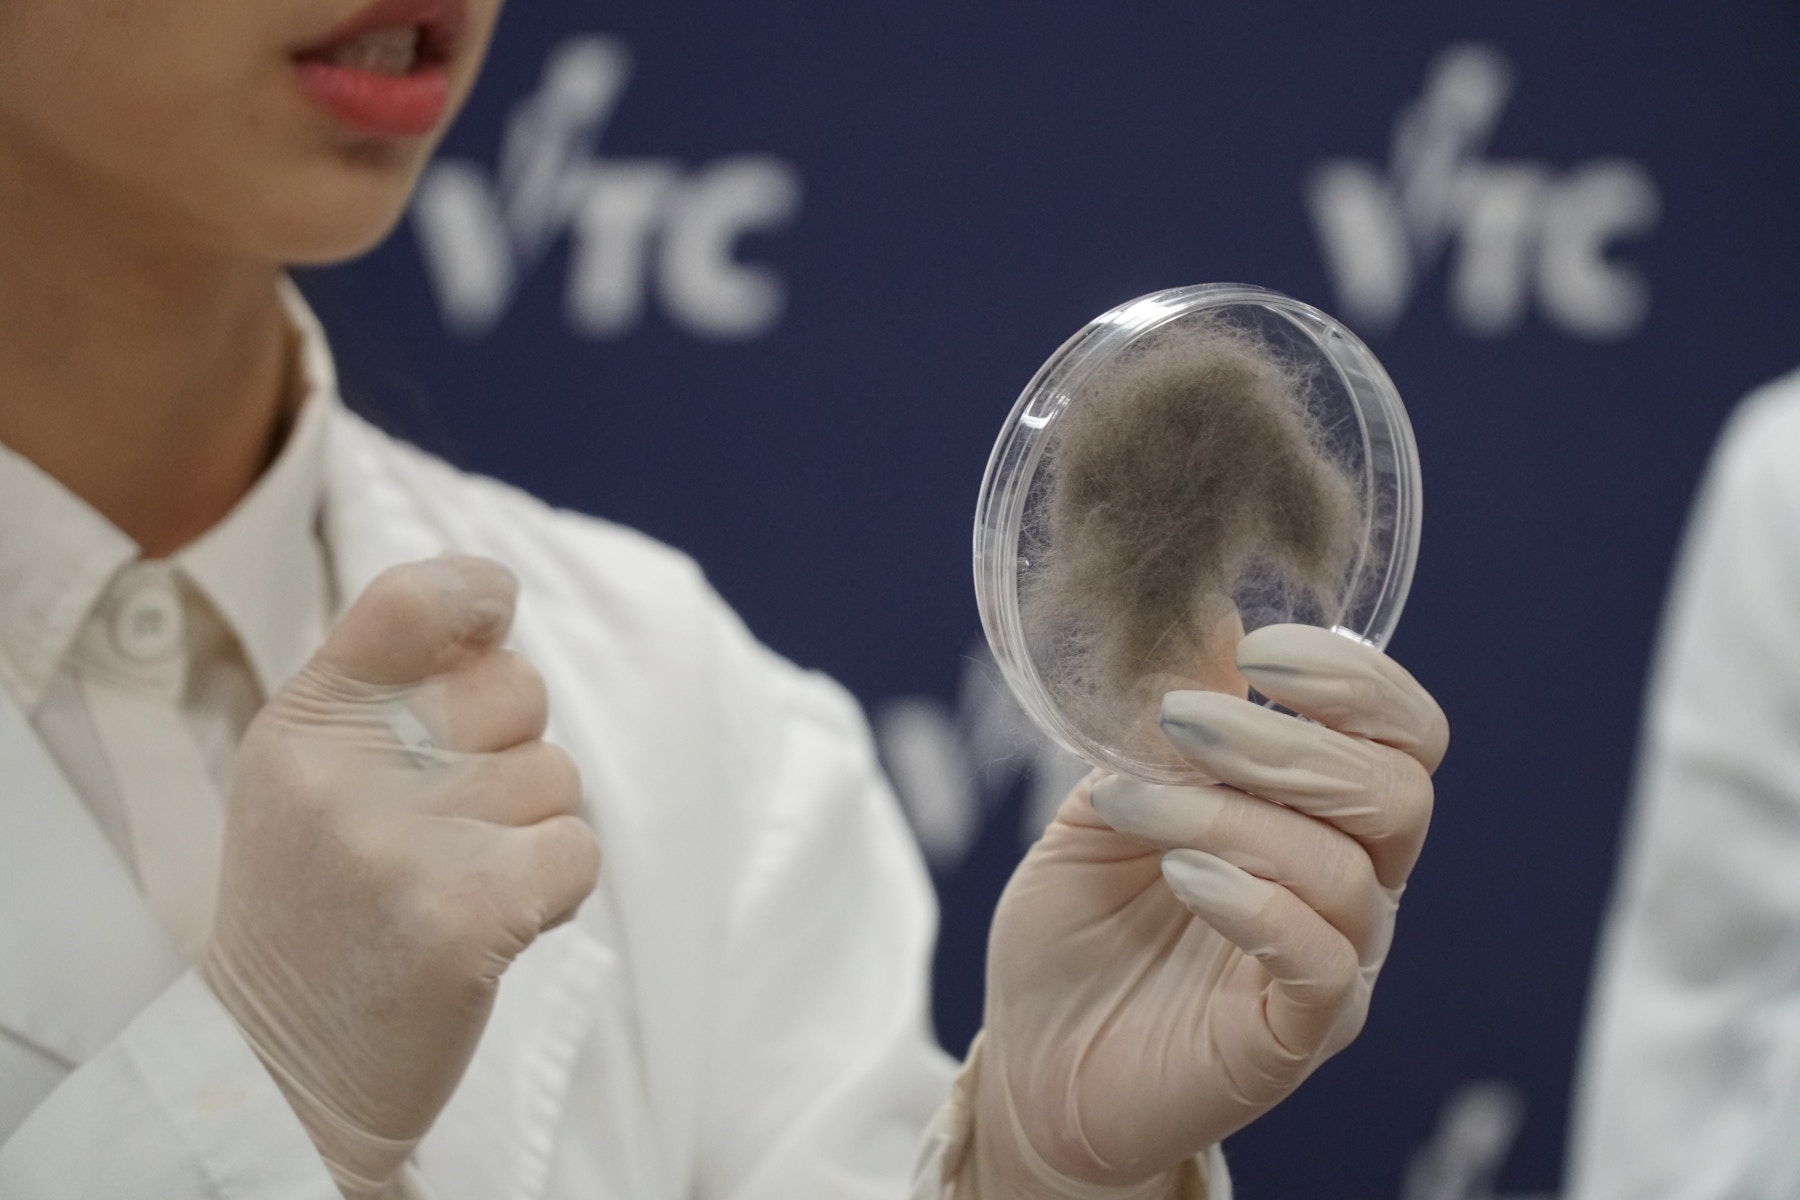
香港專業教育學院(IVE)五位就讀生物科技的同學,於本年5月成功掌握提取貓毛DNA檢測遺傳病技術,成全港首推。(鄧偉傑攝) 香港專業教育學院(IVE)五位就讀生物科技的同學,於本年5月成功掌握提取貓毛DNA檢測遺傳病技術,成全港首推。(鄧偉傑攝)

原文連結在此: https://www.hk01.com/寵物/243100/貓貓驗遺傳病抽血怕痛-ive生創-貓毛檢測法-無痛檢驗

以往要知道貓貓有否患遺傳病,需透過驗血來抽取DNA。
香港專業教育學院(IVE)5位就讀生物科技的同學與醫學研究團隊,早前發現原來透過抽取貓毛,也能分析貓隻是否患有遺傳病。對比起以往收集貓隻DNA樣本時,需收集貓隻的口腔組織和血液樣本,有機會對貓隻造成心理壓力,研究團體認為新技術對「病貓」來說,是一種較輕鬆的檢驗方法。
本港貓隻遺傳病大多分為三種,分別為多囊性腎臟病、肥厚性心肌病及漸進性視網膜萎縮症,主人一般可抽取貓貓口腔組織或抽血以檢測貓隻是否患有上述遺傳病。但有獸醫指,不少主人都欠缺為貓隻檢測遺傳病的意識,導致往往發現貓貓患病時,已錯失治療的黃金時機。
香港專業教育學院(IVE)五位就讀生物科技的同學,於本年5月成功掌握提取貓毛DNA檢測遺傳病技術,成全港首推。(鄧偉傑攝)
普遍主人忽略為貓隻檢驗遺傳病
香港專業教育學院(IVE)早前公布,5位就讀生物科技高級文憑畢業生於今年6月,成功掌握從貓毛檢測貓隻遺傳病技術,對於當初為何選擇研究這種檢測方式,作為同學們的畢業習作,其中一位研究生馮妙晉表示:「當我仲讀緊書嘅時候被安排去一間獸醫診所實習,期間見到一隻波斯貓因為遺傳咗多囊性腎病而無辦法食嘢,往往主人一發現佢哋出事嘅時候,貓貓嘅病況已經步入非常嚴重的時期,見到人類都有相應嘅方法去檢查遺傳病而寵物就比較少,因此就令我想喺呢方面做多少少,幫下貓貓佢哋。」

潘毅欣為是次研究人員之一,她表示將來將著手改善此項研究,並希望提取貓毛檢測遺傳病技術能夠被廣泛應用。(鄧偉傑攝)





新檢測方式檢驗DNA有利貓隻情緒
過往為貓隻檢測DNA,不外乎從收集貓隻口腔組織和血液樣本著手。協助同學研究是次技術的獸醫屈展邦就認為,提取貓毛檢驗是其中一種可取方法:「宜家收集貓貓嘅口腔組織或者抽取血液去檢測佢哋有無遺傳病,某程度上會為貓隻帶嚟痛楚或者構成心理壓力,但收集貓毛檢驗嘅方法就唔同,主人好容易就收集到貓毛,再將毛髮送到化驗所,就可以睇到貓隻有無患上遺傳病。」

研究團隊掌握提取貓毛檢測DNA技術後,隨即為已確診患有肥厚性心肌遺傳病及健康貓隻DNA比對,從序列間進行分析。(鄧偉傑攝)
新技術與傳統提取方式成功率相約
為令整個提取貓毛化驗DNA的技術更為準確及完整,研究團隊多次參考國外案例,並反覆實驗近200次,當中亦找來43隻貓作研究比對及研究,最終成功掌握從貓毛提取DNA的技術,成功率達75%,與傳統由口腔組織抽取DNA的成功率比較相約。
團隊掌握新技術後,便應用於確診患有肥厚性心肌遺傳病貓隻的DNA,再與健康貓隻的DNA比較,從中比對兩者序列之間的分別以及再作分析。
有份協助同學完成研究的應用科學系講師盧廷詩指,以往以毛髮提取DNA的技術主要應用於法證科學上,鮮有用於醫療領域上,「呢一種(提取貓毛)非入侵式嘅DNA提取技術某程度上,係香港獸醫學界可以話係比較前瞻嘅,我亦都期望將來可以拎到更多貓隻DNA嘅序列樣本,以及擴大我哋嘅DNA資料庫,去畀同學將來繼續研究。」

是次以貓毛DNA檢測遺傳病技術由蘇潔宜(左一)、潘毅欣(左二)、盧廷詩講師(左三)、屈展邦醫生(左四)、孫凱茵(右三)、馮妙晉(右二)及成鎵慧(右一)一同研究合作。